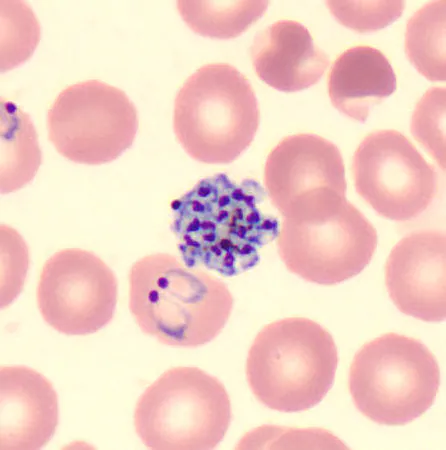
Case424_D.jpg

Case #424 – July 2016
A 22-month-old child presented to the emergency room after 10 days of cyclic fever and chills, decreased PO intake, and seizures. The child had emigrated from a country in the Middle East with her family three months prior. Blood specimens were collected for routine work-up. A CBC was flagged for low platelet count, and smears were made and stained with Wright-Giemsa. During microscopic examination of thin smears, a technologist identified possible malaria parasites. Images were captured and sent to the DPDx Team for diagnostic assistance. Figures A-F show six of the images received for consultation. What is your diagnosis? Based on what criteria?

Figure A

Figure B

Figure C
Figure D

Figure E

Figure F
This case and images were kindly provided by Texas Children’s Hospital, Houston, TX.
DPDx is an educational resource designed for health professionals and laboratory scientists. For an overview including prevention, control, and treatment visit www.cdc.gov/parasites/.